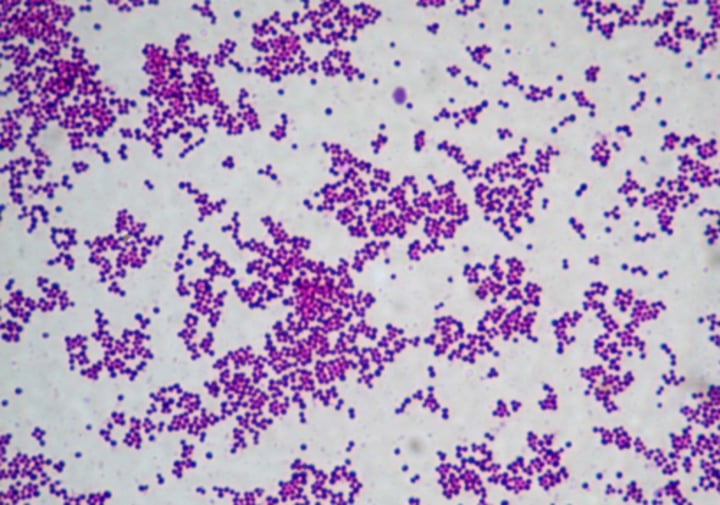
<p>Type?</p>

Lab Practical - The Megastudy List
1/338
Earn XP
Description and Tags
Name | Mastery | Learn | Test | Matching | Spaced | Call with Kai |
|---|
No analytics yet
Send a link to your students to track their progress
339 Terms
Eukarya - Fungi
Domain? Type?

Plantae
Kingdom?

Monocotyledons, angiosperms
Type? Phylum?

Cnidaria, mouth
Phylum? Pointing to?

Chelicerata
Subphylum

Bilateria
Clade

Deuterostomia
Superphylum

Deuterostomia
Superphylum

yes (brown algae are complex multicellular)
Stramenopiles multicellular
Paramecium
Alveolates example organism (1)
Rhizopus
Zygomycota example organism (1)
ovules

Bacteria
Domain?

Staphylococcus
Type?
Bacteria
Domain?

Streptobacillus
Type?

Spirillum
Type?

Eukarya - Protist
Domain?

Stramenopiles
Superkingdom?

Amoebozoans
Superkingdom?

Fungi
Kingdom?

Zygomycetes - Yes
Phylum? Monophyletic?

Fungi
Kingdom?

Bryophytes, Marchantiophyta
Phylum? Division?

Fern, Pteridophytes
Name? Phylum?

Sporophyte developing from Gametophyte
Pteridophytes
What is this? What phylum?

Magnolids, angiosperms
Type? Phylum?

Monocotyledons, angiosperms, female
Type? Phylum? Sex?

Eudicots, Angiosperms
Type? Phylum?

collar cell layer

Cnidaria, ectoderm
phylum? Pointing to?

cnidaria, coelenteron (gut)
phylum? pointing to?

Platyhelminthes
Phylum?

cephalopods, clams, scallops, mussels, slugs and snails
Mollusks include
Bilateria
clade

Cephalochordata
Subphylum

atriopore

Tunicata
Subphylum

yes
Platyhelminthes tissues
no
Platyhelminthes molting?
deuterostome
Chordata protostome or deuterostome
oogonia

Fungi, Zygomycota
Identify

zygosporangia

fungi, ascomycota
identify

basidiospores

basidiospores

no
bacteria eukaryote
no
Archaeplastida hyphae
yes
Basidiomycota multicellular
Saprolegnia
Stramenopiles example organism (1)
n
ploidy of area referenced by arrow?

bryophyta moss, male gametophyte head
identify?

female gametophyte head
identify

2n
ploidy of area referenced by arrow?

antheridia (n)
identify with ploidy

pinus pollen, n
identify and find ploidy

cone axis (2n)
identify and tell ploidy

n
ploidy of area referenced by arrow?

monocotyledon, angiosperm
identify

monocotyledon, angiosperm
identify

monocyledon, angiosperm anther
identify

pollen grains (n)
identify and tell ploidy

monocotyledon, angiosperm, ovary
identify

no
Non-vascular Seeds?
yes
Angiosperm vascular tissue
yes
Angiosperm flowers?
porifera
identify

epidermal layer

Bacteria
Domain?

Ascomycetes
Phylum?

Plantae, Bryophytes
Kingdom? Phylum?

Plantae, Bryophytes
Kingdom? Phylum?

Female
Sex?

n
Ploidy?

Male?
Sex?

Female
Sex?

cycad, Gymnosperm
Type? Phylum?

Porifera
Phylum

flatworm, mouth
type? pointing to?

Annelida, coelom
phylum? pointing to?

Nematoda
Phylum

wings

sea stars, brittle stars, sea urchins, sea cucumbers
echinoderm
lanclet (Chordata)
identify?

pharyngeal gill slits

Chordata
Phylum

neither
Cnidarian protosome or deuterostome
no
cnidarian
molting
no
cnidarian
coelom
bilateral
Platyhelminthes symmetry
no
Platyhelminthes coelom
yes
Arthropoda tissues
protostome
Arthropoda protostome or deuterostome
yes
Arthropoda molting
sporangia

hyphae

no
bacteria multicellular
no
bacteria hyphae
no
alveolates multicellular